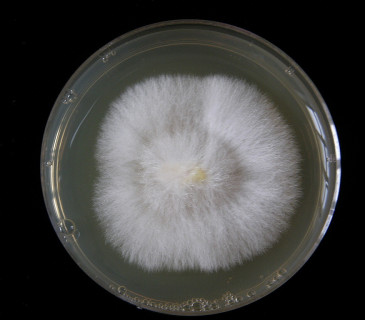
Mycelium dřevomorky na agarovém médiu, laboratoř ÚOLM LDF Brno 2010.

Serpula lacrymans (Wulfen) J. Schröt.
SYNONYMUM: Merulius lacrymans (Wulfen) Schumach.
VÝSKYT: nebezpečná hlavně v obydlených budovách, porůstá opracované dřevo jehličnanů i listnáčů, nachází se i ve volné přírodě.
SYMPTOMY A BIONOMIE: plodnice rozlité, 2 až 10 mm tlusté, na okraji s vyšším bělavým plstnatým valem, vzácně může vytvářet i odstávající klobouky, rouško tvořeno zlatooranžovými, žlutohnědými až tmavě červenohnědými nebo olivově hnědými póry, které jsou velké, otevřené nebo uzavřené. Plodnice narůstá velice rychle, ale většinou až po delší době kolonizace substrátu. Vytváří tmavé myceliové provazce, kterými čerpá vodu ze vzdálenějších míst, takže může narůstat i na relativně suchých substrátech. Má hnědou, kostkovitou hnilobu.
VÝZNAM A OCHRANA: častá v nevětraných místnostech, sklepech, budovách, porůstá dřevo, dřevotřísku, papír, textilie, zdivo. Často neplodí, ale rozklad dřeva je přesto velmi intenzivní. Doporučuje se odstranění napadeného materiálu a především zdroje vlhkosti.